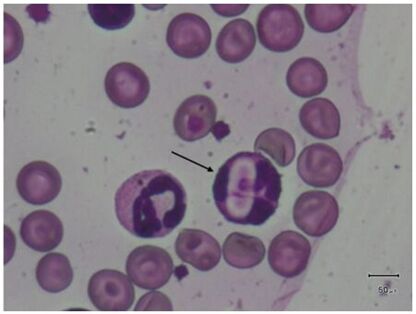
682d946fa0e55.jpg
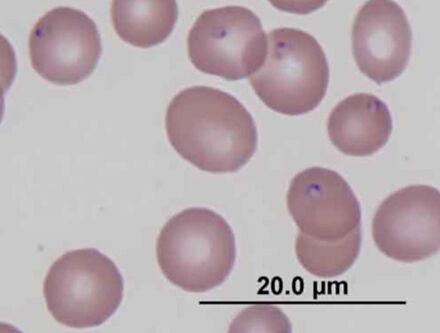
682d9484f3d94.jpg
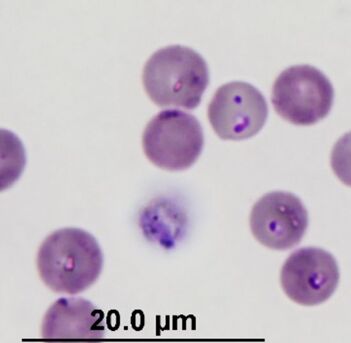
682d949380fe6.jpg

62.下列有關犬艾利希體(Ehrlichia canis)之敘述,何者錯誤?
(A)由壁蝨媒介傳播
(B)主要感染之標的細胞是單核球
(C)可投予抗生素治療
(D)病原是原蟲
答案:登入後查看
統計: A(22), B(336), C(182), D(1379), E(0) #832258
統計: A(22), B(336), C(182), D(1379), E(0) #832258
詳解 (共 4 筆)
#1611342
D) 格蘭氏陰性,立克次體
38
0
#6430038
血液寄生蟲&立克次體寄生位置分類
Ehrlichia canis:Mono、Marcophage
Ehrlichia platys:血小板
Ehrlichia ewingii:顆粒球
Ehrlichia chaffeensis:Mono
Hepatozoon:Mono、Neu

Anaplasma platys:血小板
Anaplasma phagocytophilum--嗜中性球性
Babesia:RBC

Babesia canis 犬大焦蟲(紅血球內) Babesia gibsoni 犬小焦蟲(紅血球內)
Cytauxzoon felis:RBC

Leishmania:Marcophage
補一個完整一點的血液寄生生物的內容
Ehrlichia canis:Mono、Marcophage
Ehrlichia platys:血小板
Ehrlichia ewingii:顆粒球
Ehrlichia chaffeensis:Mono
Hepatozoon:Mono、Neu
Anaplasma platys:血小板
Anaplasma phagocytophilum--嗜中性球性
Babesia:RBC
Babesia canis 犬大焦蟲(紅血球內) Babesia gibsoni 犬小焦蟲(紅血球內)
Cytauxzoon felis:RBC
Leishmania:Marcophage
補一個完整一點的血液寄生生物的內容
4
0